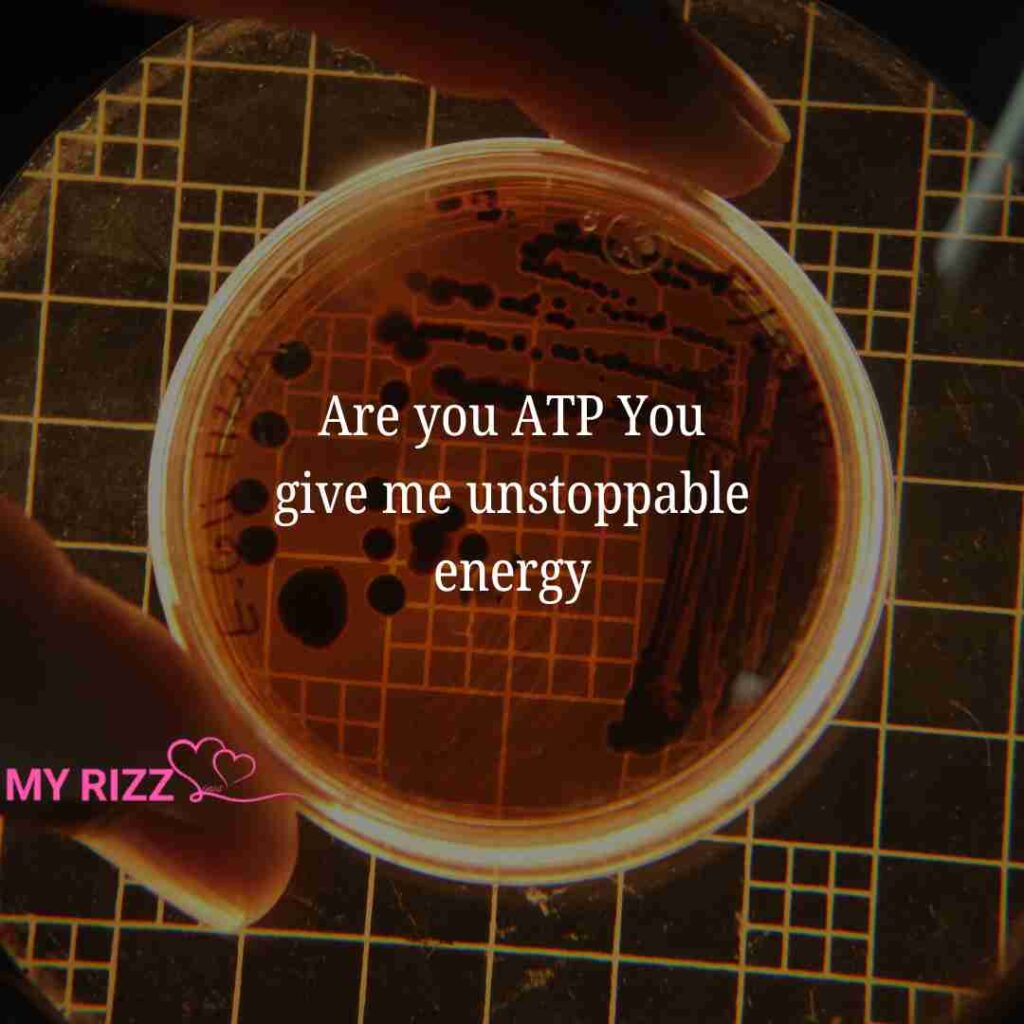

Welcome to myrizzlines.com, where smart words meet smooth confidence and simple Biology Pick Up Lines turn science into instant attraction. If you really want to impress your crush, why not use a little biology to spark that connection? After all, nothing grabs attention faster than mixing intelligence with playful charm in the most unexpected way.
Biology isn’t just about cells, DNA, and lab experiments it’s full of clever, funny, and flirty lines that work perfectly as cool ice breakers or subtle ways to get your crush smiling. Science pick up lines are also a great way to show off your intelligence. And let’s be honest, nothing is more attractive than a well-formed brain with a little confident rizz.

You light up my neurons like an action potential.

You’re sweeter than glucose in my bloodstream.

Are you mitochondria? You’re the powerhouse of my heart.

I’m drawn to you like an electron to a proton.

You must be photosynthesis, you make me feel alive.

You’re my missing allele in the gene of love.

Are you a ribosome? You make my heart synthesize happiness.

You’ve got more beauty than a perfect double helix.

I must be an organelle, I revolve around you.

You make my synapses fire nonstop.
Are you ATP? You give me unstoppable energy.

You’re the oxygen to my cellular respiration.

Are you mitosis? My feelings keep multiplying.

You must be chlorophyll, you brighten my world.

You’re the enzyme speeding up my heartbeat.

Are you DNA replication? You just doubled my love.

You’re the nucleus at the center of my universe.

I can’t function without you, just like a cell without energy.

Are you hemoglobin? You carry my love everywhere.

You’re the serotonin boosting my mood instantly.

Are you a catalyst? You started a reaction in me.

You’re the protein my heart has been coding for.

Are you osmosis? I’m naturally pulled toward you.

You’re the dominant trait in my love story.

Are you glycolysis? You break down all my walls.

You’re the spark in my nervous system.

Are you evolution? My world improved when you appeared.

You’re the membrane protecting my fragile heart.

Are you a chromosome? I feel perfectly paired with you.

You’re the biodiversity that makes my life colorful.

Are you a hormone? You control my emotions.

You’re the heartbeat in my biological rhythm.

Are you a stem cell? You give me endless hope.

You’re the glucose fueling my every thought.

Are you the Golgi apparatus? You package my happiness perfectly.

You’re the mutation that changed my life beautifully.

Are you diffusion? My love spreads toward you naturally.

You’re the capillary closest to my heart.

Are you cellular respiration? You keep my love alive.

You’re the double helix twisting perfectly with mine.
Are you a microscope? You make everything clearer.
You’re the ecology where all my feelings connect.
Are you homeostasis? You keep my world balanced.
You’re the fossil I’ve been searching for.
Are you RNA? You translate my emotions perfectly.
You’re the adrenaline rushing through my veins.
Are you natural selection? You’re clearly the best choice.
You’re the neuron completing my circuit.
Are you genetics? You’ve coded yourself into my heart.
In the biology of love, you’re my perfect match.
Cute Biology Pick Up Lines
You’re sweeter than glucose on a happy day.
You must be chlorophyll, you brighten my life.
Are you a nucleus? You’re my center.
You’re the ATP that powers my smile.
You make my neurons dance with joy.
You glow brighter than a stained microscope slide.
You’re my favorite chapter in biology.
You keep my heart in perfect balance.
Funny Biology Pick Up Lines
Are you a lysosome? You broke down my defenses.
You must be mitosis, my heart keeps doubling.
Are you diffusion? I drift toward you.
You’re like a virus, stuck in my thoughts.
Are you a petri dish? I’m growing on you.
You’re better than any lab experiment.
Are you evolution? I upgraded my standards.
You’re my forever lab partner.
Romantic Biology Pick Up Lines
You must be oxygen, I can’t breathe without you.
You’re the heartbeat in my biological rhythm.
Are you hemoglobin? You carry my love.
You’re my perfect chromosome pair.
You keep my feelings alive like respiration.
You complete my double helix.
You’re written deep in my DNA.
You make my world biologically beautiful.
Flirty Biology Pick Up Lines
Are you a hormone? You control my mood instantly.
You must be adrenaline, my heart races near you.
Are you serotonin? You make me feel high on happiness.
You’re like an enzyme, you speed things up between us.
Are you osmosis? I can’t stop moving closer to you.
You must be a neuron, you’ve wired straight into my heart.
Are you capillaries? You stay close to my heart.
You’re the chemistry I never want to escape.
Nerdy Biology Pick Up Lines
Are you the Golgi apparatus? You package my joy perfectly.
You’re like an enzyme, you make everything faster and better.
Are you a synapse? There’s electric chemistry between us.
You’re the mutation I secretly wished for.
Are you genetics? You’re my destiny.
You’re the best selection nature ever made.
You’re coded into my system permanently.
You balance my emotional homeostasis.
Smart Science Rizz Lines
Are you a microscope? You make life crystal clear.
You’re the ecosystem of my dreams.
Are you natural selection? You’re the obvious best choice.
You’re like RNA, translating my hidden feelings.
Are you ATP synthase? You spin my world around.
You’re the protein my heart keeps building.
You’re my favorite biological reaction.
You’re the formula to my forever happiness.
We’re glad you stopped by and explored these Biology Pick Up Lines with us. Each line is written to feel smart, smooth, and naturally confident never forced, never awkward. Whenever you need clever words that mix intelligence with attraction and turn simple moments into memorable ones, myrizzlines.com will always be here to help you choose the perfect rizz for the right vibe.
Also Read About: French Pick-Up Lines || Basketball Pick-Up Lines || Valentine’s PickUp Lines


